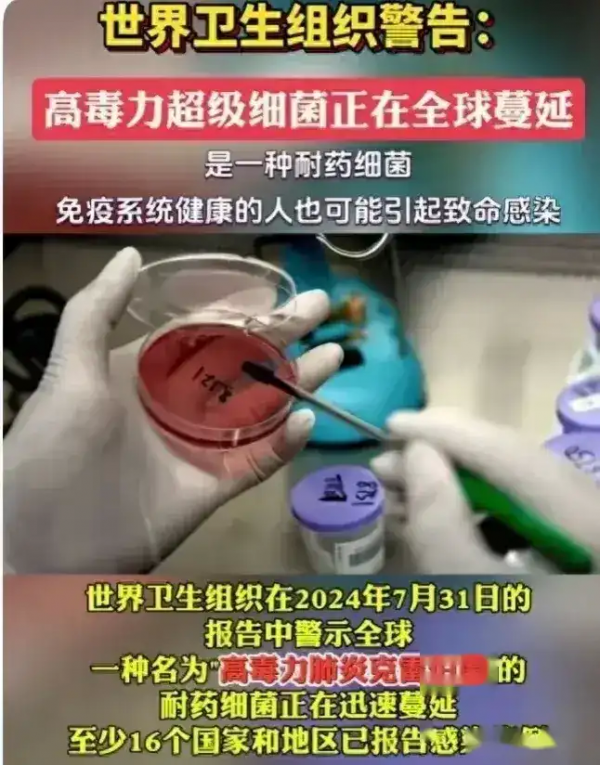

新冠病毒变种蔓延
自从新冠病毒出现以来,就一直没有停止过变异的脚步。而在这期间,也确实出现了不少的变种病毒,只不过并没有引起太大的关注。
就在2023年的时候,却又出现了一种"耐药细菌"的病毒,而且这种病毒的毒力非常的大,一旦感染的话,就会出现肺炎、咳嗽等症状。
据世卫组织的报告显示,这种"耐药细菌"的病毒已经开始在全球范围内蔓延,而且还具有很强的传染性,所以一旦蔓延开来的话,对于全球的疫情形势来说,肯定是非常不利的。而且,根据84个国家的哨点监测数据来看,这几个星期以来,检测出这种"耐药细菌"的病毒呈阳性的百分比一直在上升,尤其是在欧洲地区,已经超过了20%。


世卫组织的呼吁
面对这种情况,世卫组织也是第一时间发布了提醒通知,呼吁全球各国要高度重视起来,而且还要加强对于这种病毒的监测工作。因为目前来看,对于这种"耐药细菌"的病毒,各国的医疗机构对它的了解还非常的有限,所以也无法对它进行有效的防控工作。

而世卫组织也怀疑,这种"耐药细菌"的病毒可能已经在全球范围内扩散开来,只不过现在还没有被及时的检测到而已。对于各国来说,要想要尽快的控制住这种病毒的蔓延,就必须要加强国际合作,共同研究并制定更加有效的防控措施。

个人防护的重要性
除了加强国际合作之外,世卫组织还特别的强调了个人防护的重要性。因为在这场疫情中,无论是什么样的病毒,最终的传播途径都是人。所以只要每一个人都能够养成良好的防护习惯,就能够有效的减少病毒的传播。

而要想要做到这一点,教育宣传工作就显得尤为的重要了,各国的相关部门需要进一步加强对于防护措施的宣传,让公众能够更加的了解到病毒的传播途径,以及应该如何正确的进行防护。只有这样,才能够在最短的时间内,控制住病毒的蔓延。


疫苗接种工作
为了更好的控制病毒的蔓延,疫苗接种工作也是非常的重要。而世卫组织也特别的呼吁各国要加快疫苗的研发和接种工作,只有当足够多的人群都接种了疫苗之后,才能够有效的提高人群的免疫力,从而减少病毒的传播和感染风险。

而为了更好的应对突发传染病的威胁,各国之间的合作也是非常的重要。只有建立了更加紧密的国际疫情防控合作机制之后,才能够更好的维护全球的公共卫生安全,共同应对各种突发传染病的威胁。

结语
新冠病毒的变种正在蔓延,这对于全球的疫情形势来说,无疑是一个非常大的挑战。而要想要尽快的控制住病毒的蔓延,就需要全球各国共同努力,加强合作,共同抵御病毒的侵袭。而作为普通人来说,也一定要重视起来,养成良好的防护习惯,只有这样,才能够在最短的时间内,战胜病毒,迎来真正的胜利!










